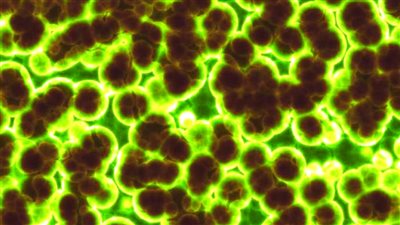

مأساة امرأة أصيبت بتعفن الدم وتسبب في بتر أطرافها

تعرضت جوليانا برانسدن لأزمة صحية مفاجئة بدأت باعتقادها أنها مجرد إنفلونزا، لتكتشف فيما بعد أن حالتها أخطر من ذلك بكثير.
تعفن الدم
وبحسب صحيفة "الصن" البريطانية، قالت أختها إن جوليانا كانت تتمتع بصحة جيدة إلا أنها انهارت فجأة عند إسعافها وتوقف قلبها خلال نصف ساعة مرتين.
وأخبر الأطباء عائلتها أنها تعرضت لصدمة إنتانية وستبقى على جهاز التنفس الاصطناعي بوحدة العناية المركزة مدة 66 يوما.
وكافحت جوليانا بشدة الصدمة الإنتانية وفشل الأعضاء، لكن الأطباء اكتشفوا أيضا حالة سيئة من الالتهاب الرئوي والإنفلونزا والبكتيريا العقدية الغازية.
وبعد استيقاظها من الغيبوبة، اضطر الأطباء إلى بتر ساقي جوليانا وستفقد للأسف معظم أصابعها أيضا.
ما هو تسمم الدم؟
يشير كلا المصطلحين تعفن الدم وتسمم الدم إلى عدوى الدم التي تسببها البكتيريا عادة، ويمكن أن يؤثر الإنتان على أعضاء متعددة أو على الجسم بأكمله.
ويمكن أن يحدث الإنتان أيضًا بسبب عدوى فيروسية أو فطرية، على الرغم من أن الالتهابات البكتيرية هي السبب الأكثر شيوعا إلى حد بعيد.
وقبب وقت سابق اكتشف علماء أستراليون إنزيمًا يحول الهواء إلى كهرباء، ما قد يؤدي إلى فتح مصدر غير محدود من الطاقة النظيفة.
ووجد فريق جامعة موناش في ملبورن بأستراليا أن إنزيمًا مستهلكًا للهيدروجين من بكتيريا التربة الشائعة قادر على توليد تيار كهربائي باستخدام الغلاف الجوي كمصدر للطاقة، حسب «روسيا اليوم».
وقال البروفيسور كريس غريننج، من معهد اكتشاف الطب الحيوي بجامعة موناش في ملبورن: «لقد عرفنا منذ بعض الوقت أن البكتيريا يمكنها استخدام أثر الهيدروجين الموجود في الهواء مصدرًا للطاقة يساعدها على النمو والبقاء، بما في ذلك تربة أنتاركتيكا. وأظهر الفريق أن الإنزيم المسمى Huc أثبت أنه «مستقر بشكل مذهل» وفعال بشكل ملحوظ في توليد «طاقة من الهواء الرقيق».
وتركت قمة المناخ، مؤتمر الأطراف السابع والعشرين المنعقد بمدينة شرم الشيخ نوفمبر الماضي، زخمًا كبيرًا في مجالات الطاقة المتجددة تنوع بين الإمداد بالطاقة الكهربائية النظيفة أو دخولها كحافز لتحسين الواجهة الاستثمارية لبعض المشروعات؛ كالهيدروجين الأخضر والأمونيا.
ونقدم لكم من خلال موقع "فيتو"، تغطية ورصدًا مستمرًّا على مدار الـ 24 ساعة لـ أسعار الذهب، أسعار اللحوم، أسعار الدولار، أسعار اليورو، أسعار العملات، أخبار الرياضة، أخبار مصر، أخبار الاقتصاد، أخبار المحافظات، أخبار السياسة، أخبار الحوادث، ويقوم فريقنا بمتابعة حصرية لجميع الدوريات العالمية مثل الدوري الإنجليزي، الدوري الإيطالي، الدوري المصري، دوري أبطال أوروبا، دوري أبطال أفريقيا، دوري أبطال آسيا، والأحداث الهامة والسياسة الخارجية والداخلية، بالإضافة للنقل الحصري لـ أخبار الفن والعديد من الأنشطة الثقافية والأدبية.